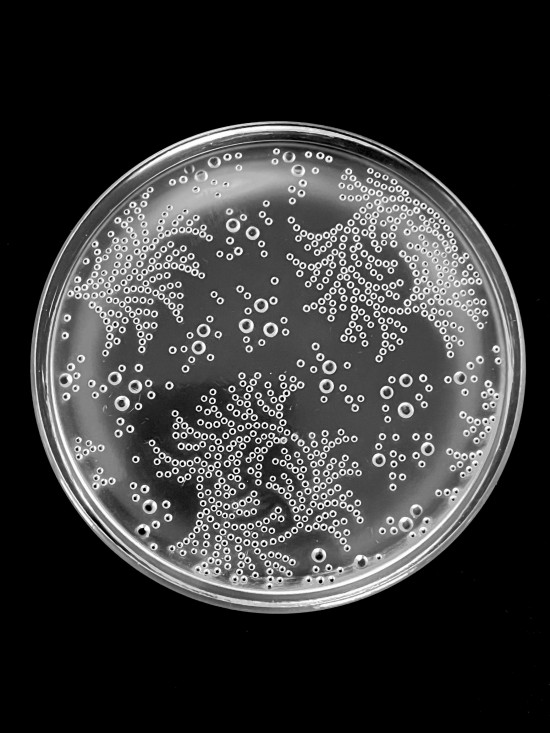
1

Verlys - Art Déco Glass Powder Box
$365 AUD
Item 3395
An Art Déco glass box & cover. The lid intaglio moulded on the underside with a stylised bubble design.
Moulded mark 'Verlys, France'.
French, C1930.
CONDITION: Very good.
DIMENSIONS: 12cm Diameter
AVAILABILITY: In stock
ENQUIRE ABOUT THIS ITEM & SHIPPING COSTS >